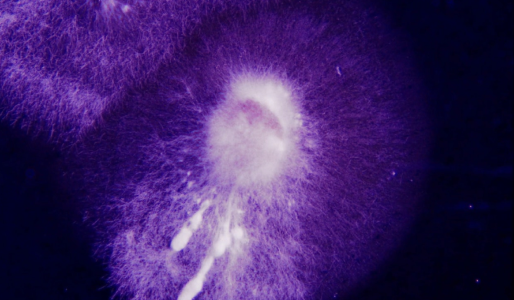

Anbefaling: Ti film du ikke må misse i Odense
I Heks kommer den lille pige Esther i klemme, da hendes mor og mormor bliver rygende uenige om, hvorvidt hekseafbrænding er upassende eller en hyggelig tradition.
Odense International Film Festival (OFF) har i år modtaget 4.140 kortfilm – rekord for festivalen – og de er blevet skåret ned til de 148 ypperste, som fra 26. august til 1. september kan opleves i Odenses biografer.
Festivalgængere i den fynske hovedstad kan se frem cremen af dansk kortfilm og håndplukkede perler fra det store udland.
En særlig udvalgt gruppe konkurrerer om de eftertragtede OFF-awards, som uddeles af festivalens jury den 31. august.
Vinderen i de forskellige kategorier (med undtagelse af ungdomskategorien) er foruden den odenseanske hæder også sikret en plads i kapløbet om en Oscar-kvalifikation.
Danmarks ældste filmfestival samarbejder igen i år med FilmAkademiet, der står bag Robert-prisen. Så ud af de danske OFF-film fra 2024 har Akademiet shortlistet ti til en Robert.
Selv den mest ivrige festivalgænger får svært ved at nå det hele, så Ekko anbefaler nogle af de mest spændende kortfilm, som vises i den danske hovedkonkurrence på det store lærred og på festivalens streamingside, Offstream, i den kommende uge.
Unfold

Ved sidste års Ekko Shortlist Awards blev den intense psykiatrifilm Et eksempel: Dem på gulvet den helt store vinder efter også at have triumferet i Odense. I år vender instruktør Selma Sunniva tilbage til festivalen, og forventningerne er høje.
Initiativet til den helt særlige kortfilm Unfold kommer fra komponisten Rasmus Christian Pedersen.
Visionen er at efterligne den kreative leg, hvor man folder et stykke papir sammen og på skift tegner skjulte dele af et menneske. Til sidst glatter man papiret ud og afslører et miskmask af nogenlunde sammenhængende legemsdele.
På samme vis er filmen instrueret af tre instruktører, Sunniva, Nicolai G.H. Johansen og Óskar Kristinn Vignisson, der ikke har set hinandens sektioner.
Både Johansen og Vignisson har tidligere brilleret på Ekko Shortlist med henholdsvis Hvis du vidste og Frie mænd, og sammen med Selma Sunniva har de lavet en surrealistisk og intens fortælling med en flippet visuel stil.
Unfold kan ses i filmblokken DK4.
Sporehuset
Frigge Fri er uddannet flerkamerainstruktør fra Den Danske Filmskole og vender og drejer altid nysgerrigt sine emner til ugenkendelighed. Det er også tilfældet med den flippede Sporehuset.
Instruktøren er allerede på Ekko Shortlist med Otgon, om en lille piges kamp for at uddanne sig til slangemenneske, og hendes første lange dokumentar, Klub Kranium, blev vist på Cph:Dox i 2021 og fejede benene væk under publikum med sit visuelle portræt af et følsomt goth-fællesskab.
House of Spores mediterer over begrebet ”sporer”, og det føles nærmest, som om man selv er en, når fotograf Emil Aagaard på en blæret og svævende måde følger luften, der flyder mellem lokaler.
Sporehuset kan ses i filmblokken DK1.
Heks

Med en bragende messe af Bach sætter Agnes Triers Heks tonen an for det drama, der venter den lille pige Esther hjemme hos hendes mormor.
Mormoren, spillet af Bodil Jørgensen på karakteristisk slap line, prøver at gøre Sankthansaften til noget særligt som i de gode gamle dage, og det involverer en klassisk hekseafbrænding.
Esthers mor (Johanne Louise Schmidt) finder det ikke passende, og med bitre, modstridende præstationer indrammer Schmidt og Jørgensen de stridigheder, familier har over hele landet
Med sin afgangsfilm fra Filmskolens animationslinje i 2020, Gossip, imponerede Agnes Trier med gennemtænkte karakterer, og samme tilgang har fået Heks shortlistet til en Robert.
Heks kan ses i filmblokken DK5.
Heartbeats

En anden Robert-shortlistet film er Thor Zings Heartbeats.
Instruktøren står også bag kortfilmene Når verden bøjer og Jorden kalder, der henholdsvis har vundet og været nomineret til en Ekko Shortlist Award for fotografering, så det er en stor billedskaber, vi har med at gøre.
Hans nye film følger en tilfældig dag, der udvikler sig til et mareridt. I familiehjemmet falder Thildes far om med hjertestop. Og mens hun og hendes søster må blive hjemme, haster deres mor afsted til hospitalet.
Filmen skildrer hjerteslag og liv, men først og fremmest den ulidelige ventetid, stilhed og død, der hænger i luften, mens man venter på livstegn.
Heartbeats kan ses i filmblokken DK4.
Sprællemanden

Attenårige Alexander (Elias Budde Christensen) er hevet med til en psykiater, fordi hans far tror, at han er psykisksyg.
I sekvenser ser vi Alexanders helt normale hverdag, der er ved at flyde over med lektier, gruppepres, alkohol, piger, hjertebanken og skoletræthed. Samtidig hænger hans fars bebrejdende blik tungt over den unge gut, der kæmper for at få sit liv til at hænge sammen.
Selv om OFF anbefaler, at filmene i den danske konkurrence ikke bør ses af børn under 16 år, burde samtlige større skolebørn have Gustav Werners Robert-shortlistede Sprællemand på undervisningsprogrammet.
Line Kruse, Ken Vedsegaard og Alexander Clement er at finde på rollelisten i det rørende familiedrama, der har samtale, angstanfald og misforståelser på plakaten.
Sprællemand kan ses i filmblokken DK2.
Søger Hwa Sun

Det dybt personlige værk har været længe undervejs for skuespiller og kortfilmsinstruktør Sandra Yi Sencindiver.
Som hun har fortalt til Ekko, er Søger Hwa Sun baseret på instruktøren og hendes tvillingesøsters turbulente barndom med adoptivmoren Hwa Sun.
I flashbacks ser man, hvordan Hwa Sun kæmper med et omskifteligt kærlighedsliv og i afmagt afstraffer sine to unge døtre på fysisk vis.
Kortfilmens fortællestil er kompleks og mørk, og det har krævet tid at modne historien – både kunstnerisk og følelsesmæssigt.
Slutningen lægger op til debat og vil få publikum i Odense til at vende sig mod sidemakkeren for at få afgjort, hvad der egentlig lige skete.
Søger Hwa Sun kan ses i filmblokken DK9.
Intet vover

Et lige så personligt projekt finder man i den monsterambitiøse og satsede Intet vover.
Filmen er skabt af manden bag flere Star Wars-kortfilm, Jesper Tønnes. Denne gang udforsker han ikke udkanten af galaksen, men de ydre grænser for de analoge filmformater Super 8, Super 16, 35mm og det legendariske 65mm-format.
Fortællingen er en skøn krimi-noir om en mystisk kuffert, der på dramatisk og voldelig vis skifter hænder. Hvad den indeholder, holdes godt skjult ligesom i Tarantinos Pulp Fiction.
Som Jesper Tønnes har for vane, har han tiltrukket nogle vilde navne til sit passionsprojekt. Intet vover byder på underholdende, overdrevne og genretypiske præstationer fra Nicolas Bro, Jens Jørgen Spottag, Fanny Leander Bornedal, Maria Erwolter, Ali Najei og Carsten Bjørnlund.
Intet vover kan ses i filmblokken DK2.
Wild Child

Instruktør Sif Lina Lambæk har en helt vidunderligt konceptuel tilgang til sine projekter.
Hun har tidligere imponeret med Ekko Shortlist-filmen Halbal og har nu slået sig sammen med Super16-klassekammeraten, Kristine Plechinger Tüchsen, som er udannet manuskriptforfatter på linjen har skrevet Selma Sunnivas Et eksempel: Dem på gulvet.
Wild Child følger en bande unge børn i en små-dystopisk fremtid, hvor der ikke længere findes voksne, og den slags scenarier plejer at ende med vold og anarki a la Fluernes Herre.
Men i denne omgang kan børnene godt klare sig selv i en verden, der er blevet kørt i sænk af ældre generationer, som hverken passede på dem eller kloden. At kalde kortfilmen for ”tankevækkende” er en underdrivelse, og det udelukkende unge cast bliver ved med at imponere.
Wild Child kan ses i filmblokken DK5.
Takeaway

Den meget hvide, danske Pernille bestiller over telefon en omgang ”autentisk takeaway” til sig selv og sin afrikanske kæreste, Calvin. Da maden bliver bragt til døren, er det tilfældigvis af et bud, der kender Calvin fra barnsben.
Der foregår en uudtalt dialog mellem de to barndomsvenner, alt imens Pernille viser uvidende rundt i sit ekstremt nordiske og upersonlige Bo Bedre-hjem, som hun har ”hentet inspiration til fra Afrika”.
Instruktør Darshika Karunahara står også bag den medrivende First Night om to dansk-tamilske søstre, som vil have seksuel debut samme aften. Hun præsenterede idéen til First Night i 2019 på OFF, hvor hun vandt konkurrencen Pitch Me Baby.
Diem Camille er helt forrygende som buddet Sheena i Takeaway, der kort og præcist indrammer hverdagsracisme, fordomme og påtaget identitet på superakavet vis.
Takeaway kan ses i filmblokken DK8.
Daddy Tissues

Vi runder anbefalingerne af med et brag af en musikvideo, som Ekko Shortlist-vinderen Louise Hylland står bag.
Det er svært at opsummere alt, der sker på de tætpakkede tre minutter, som Nicolas Bro bruger på at smide omkring sig med kleenex af mærket ’Daddy Tissues’.
Den dansk-norske instruktør spiller selv med som leopardklædt psykolog, der forsøger at udrede en stortudende Nicolas Bro for en eller anden form for psykisk lidelse i en guldbelagt klinik.
Hylland vandt i 2022 Shortlist Prisen og Publikum Prisen til Ekko Shortlist Awards for den voldsomme og overraskende R[evol]ution of Love, der også har Nicolas Bro på rollelisten.
Daddy Tissues-sangen er allerede lagt på Spotify og er en overraskende ørehænger, som man må høre på eget ansvar.
Daddy Tissues kan ses i filmblokken DK4.
Odense International Film Festival

Danmarks ældste filmfestival, som er grundlagt i 1975.
Vinderen bliver kvalificeret til en Oscar-nominering for bedste kortfilm.
Løber af stablen 26. august – 1. september.
Læs mere på festivalens hjemmeside.
Karoline Balstrøm

Født 1996 i Emdrup, København.
Cand.mag. i Film- og medievidenskab.
Har arbejdet på DR og 24syv.
Skrevet for Ekko siden 2023.
Filmmagasinet Ekkos udsendte på OFF-festivalen.


Kommentarer